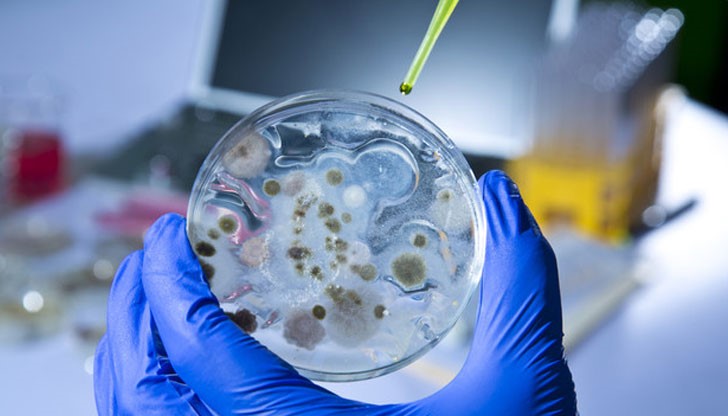
Задържани в Мароко терористи планирали серия от терористични актове в страната

Намериха биологично оръжие в терористи
- Редактор: Симона Георгиева
- Коментари: 0
У задържани в Мароко терористи, които планирали серия от терористични актове в страната, е било намерено биологично оръжие, съобщи директорът на Централното бюро за съдебни разследвания на страната Абделхак Хийям в интервю за списание "Марок Ебдо", цитирано от ТАСС и БТА.
Според него "от заловените терористи е било иззето голямо количество оръжие, включително и биологическо". Сред задържаните имало и гражданин на Франция.
"За първи път арестувахме непълнолетно момче, което трябвало да взриви парламента", каза Хийям.
Той подчерта, че мароканските служби за сигурност "продължават да полагат усилия за отразяване на всяка заплаха, която може да нанесе вреда на интересите на кралството, и на всеки престъпен план, имащ за цел да дестабилизира ситуацията".
На 18 февруари мароканското вътрешно министерство съобщи, че спецслужбите са обезвредили и арестували 10 члена на терористична клетка, а също са успели да предотвратят планирани от тях опасни терористични актове на територията на страната. Главатарят на бандата бил открит и задържан в своето нелегално жилище в Ел Джаид - пристанищен град на брега на Атлантическия океан. Там той разполагал с голям арсенал от оръжия и боеприпаси.
Арестуваните възнамерявали "да извършат серия от терористични актове срещу стратегически обекти" в Мароко, подстрекавани от терористичната организация "Ислямска държава".






















Русе отбелязва 111 години от арменския геноцид
Румен Радев събра над 42 000 гласа в Русе
Стефка Костадинова остава без място в парламента
Румен Радев събра над 42 000 гласа в Русе
Стефка Костадинова остава без място в парламента